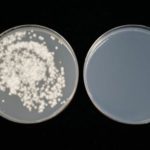

1 :2019/07/23(火) 21:39:43.89 ●
■れいわの主張に麻生氏皮肉「負担と給付考えていかねば」
麻生太郎財務相は23日の閣議後記者会見で、参院選の争点となった10月の消費増税をめぐり、
「消費税の引き上げという前提は最初から申し上げてきたから、そういった意味では信任をいただいた」と述べた。
与党が過半数を獲得した参院選の結果を受け、改めて予定通り実施する意向を示した。
参院選で野党側はそろって増税に反対。消費税の「廃止」を掲げたれいわ新選組が比例区で2議席を獲得した。
これについて麻生氏は「基本的に福祉は負担と給付のバランスの上に成り立っている。
給付を増やして負担は減らしてということが成り立つと、れいわの方は思っておられるわけでしょ」と皮肉った。
「私どもは少なくとも負担と給付のバランスは常に考えていかねばならんもんだと思っています」とも述べ、
負担増が避けられないことを強調した。(岩沢志気)
https://news.livedoor.com/lite/article_detail/16817716/
2 :2019/07/23(火) 21:40:59.86 ID:pkwU7K9E0.net
公務員に言ってやれよ
つーか税金取りすぎなんだよボケが
>>2
れいわは公務員票田ではないけど
そこは切り込めないだろうな
3 :2019/07/23(火) 21:41:11.41 ID:+vO5DxTq0.net
麻生は障碍者議員には触れるなよ
>>3
太郎のその位は分かってるだろ
多分w
まぁ間違っているけれど金持ちと企業に増税して消費税減らすといっている分共産や社民よりマシだな
ウンコと下痢ベン位の差だけど
>>3
今の世の中ジャブくらいなら支持率上がるやろw
>>3
えっ?障害者年金も税金か、ひり出されているっつー皮肉だろ?
4 :2019/07/23(火) 21:41:20.43 ID:iVyNSTnH0.net
財源考えない理想論にここまでまだ騙される老害達
若いの選挙行かねえと売国奴の国になるぞほんと
5 :2019/07/23(火) 21:44:27.33 ID:3+pNpv+10.net
一人当たりの給付が増えなくても受給者が3倍になったら負担は3倍になるからな
その辺分かれよ
ちなみに70〜74歳の団塊世代だけで1000万人だ
6 :2019/07/23(火) 21:45:05.61 ID:62fwNiXR0.net
皮肉じゃなくて事実確認でしょ
7 :2019/07/23(火) 21:47:17.37 ID:hNgftzf+0.net
なお不労所得は考えないものとする
8 :2019/07/23(火) 21:49:25.86 ID:fxNb5zIv0.net
金持ち 大企業に負担させることは別に不可能ではないだろう 金持ち 大企業が従業員や社会に利益を還元することをあまりにもしないなら社会はおかしくなるのもやむを得ない気もする
>>8
じゃお前が仕事で成功して1億稼いだら9割くらい持っていかれていいって事だな?夢を潰すこと言ってるんだぜ?
9 :2019/07/23(火) 21:49:31.85 ID:NU4ySdyj0.net
公益法人全廃
公務員の人件費3割カット
議員定数削減
これで40兆くらい浮く
11 :2019/07/23(火) 21:49:40.98 ID:AVxJH9FT0.net
働いた分は賃金を貰えるなら、何時間だって働くよ
今は金を稼ぎたいんだ
政治家は働きたくないってやつの声を聞きすぎだと思う
13 :2019/07/23(火) 21:50:27.15 ID:h9q5bpYL0.net
普通給料が上がれば物価も上がるのにな
そんな簡単な事にも本気で気付けないなんて
>>13
物価の上昇や増税に給与が追い付いてないから生活が苦しいと感じる人が増えてるんだよなぁ
>>17
増えてるって言っても微増だろ
かなり昔から殆ど変わってないぞ
14 :2019/07/23(火) 21:50:47.70 ID:n21JDdvX0.net
なお負担を増やしながら福祉を切り捨ててる模様
15 :2019/07/23(火) 21:51:21.49 ID:YNmGuH720.net
プライマリーバランスとかいう財務省の洗脳
16 :2019/07/23(火) 21:52:16.95 ID:8ylWeMON0.net
麻生より漢字も読めるし酒カスでもヤニカスでもない
おまえのポスト譲っても成立するぞw
18 :2019/07/23(火) 21:53:19.09 ID:b9UHge+R0.net
企業に負担させようとしてるじゃん
あほなのかこいつは
19 :2019/07/23(火) 21:53:59.32 ID:NU4ySdyj0.net
麻生って昔は財政健全化論者じゃなかったような
低所得者層向けの財政出動もやらんといえないとか言ってたのにな
安倍の馬鹿と組むようになってからおかしくなったな
20 :2019/07/23(火) 21:54:38.01 ID:Yw/cZuTc0.net
法人優遇しすぎた結果がコレ。法人税増やせばいいだけの話。
お前ら役人のお友達から税収増やすだけの簡単な仕事だろ。
>>20
だわな
法人税を増税すれば企業は税金で全部持ってかれるくらいならと人件費や設備投資に金まわすようになる
それで節税になるからな
こんなのは昔から言われてることなのに
>>24
ものごとの一面しかみれないのは馬鹿の証明になるからやめたほうがいいぞ
>>24
日本国内には投資しないけどな。
まあ海外工場増設でも機械は日本メーカーの入れるが、それも日本国内産ではないぞ。
>>20
友達からむしり取るとか
その時点で友達じゃないよ
22 :2019/07/23(火) 21:59:34.25 ID:2faXD3ay0.net
れいわの池沼どもに理屈が通じると思っているのか?
23 :2019/07/23(火) 21:59:36.11 ID:bNErCaIL0.net
値下げした法人税を溜め込むなって麻生さん言ってたじゃん
25 :2019/07/23(火) 22:01:51.69 ID:CEE2jwyu0.net
麻生は会社経営経験者だしね
遊んで暮らしてた山本とは経験が違いすぎる
26 :2019/07/23(火) 22:02:40.78 ID:gQvBFMAc0.net
でも議員の給付は増やします
27 :2019/07/23(火) 22:03:41.03 ID:u27oxVLb0.net
貧乏人はネトウヨやめとけよ^^
28 :2019/07/23(火) 22:03:43.13 ID:w4wPYni50.net
だから、麻生くんよ
金持ちから取るって言ってただろ
おまえが払うんだよ?
おまえは、れいわが与党になったら奪う側から奪われる側になるんだよ?
>>28
文化大革命かな
29 :2019/07/23(火) 22:04:11.04 ID:AMKFXrtU0.net
左翼の皆さん簡単に福祉!!福祉!!なんでも面倒見ろ!!って言うけど、
それもたくさんの健常者がいて成り立つんやで
補助金ビジネスやってる奴ら肥えさすだけの福祉が要らんわ
30 :2019/07/23(火) 22:04:18.40 ID:Zc6HH0Ak0.net
チoソ核派はオツム28だからw
31 :2019/07/23(火) 22:04:34.17 ID:lXwlZu7T0.net
太郎ブラザース
32 :2019/07/23(火) 22:04:55.62 ID:w4wPYni50.net
麻生セメントみたいに公共事業で太った会社から税金をもっと払っていただく
そういうことだぞ?
33 :2019/07/23(火) 22:05:00.90 ID:0EZWyXxF0.net
ネタにマジレス
35 :2019/07/23(火) 22:05:26.67 ID:n2fJaNNS0.net
共産が擦り寄ってるらしいがれいわって女系天皇賛成なの?
>>35
パチリンがメロリンを評価()してたからそうなんだろ
37 :2019/07/23(火) 22:06:19.01 ID:qvljJY950.net
所得税と法人税を上げるといえない麻生太郎
だからass hole taro
38 :2019/07/23(火) 22:06:40.65 ID:IsCtwwOK0.net
負担ばっか増やして給付を減らしてきた党の人に言われたくないわな
39 :2019/07/23(火) 22:06:45.20 ID:9phhq4wE0.net
出来らぁっ!
40 :2019/07/23(火) 22:07:10.83 ID:8MEy7iqe0.net
嘘ついて消費税上げた自民党よりは遥かに良い。
41 :2019/07/23(火) 22:07:32.35 ID:cbXpVVuL0.net
まず湯水のように使ってる無駄な金を無くせ
数兆円あるだろうが
>>41
かつての民主党と同じことを言っている馬鹿発見!

コメント
一応れいわは消費税廃止した場合に代わりになる財源を提案してるよな
それじゃ追いつかなくなったから現在の形があるんだけどな
その時代よりもより多額の税収が求められる現代に沿った案を出さんと現実味はない
ただ、正直なところ対案何一つ出さず反対のための反対しか出来ない他野党よりは現実的に見えるのが怖いな
税金って財源のためにあるんじゃないよ
再分配とインフレ抑制のためにある
政府は資金が必要なら通貨発行すればよい
消費税で負担増やして
ほとんどが法人税削減の分になってるくせにほざくなよ
全くその通りだな
加えていうなら所得税の累進性の低さだな
本来、政府が赤字になれば民間は黒字になって乗数効果を生んで税収が増える
ところが所得税と法人税が低いから、いくら政府が国債を発行しても一部の金持ちと大企業にブタ積みされるだけ。結果デフレが起こった。
消費税を廃止して、数千万円の所得に60、70パーセントの所得税率、法人税を40パーセント台、金融所得課税を所得課税に、要は昭和に戻せばいい。
金持ちは逃げると反論するかもしれないが、今の中国を見てみろよ。
ガチガチに外国企業を縛っても国内景気が良いから、外国企業も撤退できないじゃないか。
麻生「法人税を減らせば、消費税を増やしてバランスとるのは当然である」
累進課税の復活と消費税についても、贅沢品と生活用品で分ければ良いと思うんだけどね。
何でも平等で一律だと、低所得者が割を見るだけだからね。
まずは要介護の重度障害者を国会に送り込んで無駄に税金浪費させるアホな政党潰してからだな
とりあえず植物人間に対する超高額医療止めようぜ
災害対策の名目で行われてる無駄な公共事業を無くしてその金を社会保障に回せばいいだろ?
1000年に一度の大災害に備えて全国各地にダムや堤防や防潮堤を作るなんて馬鹿げている。
それに政府が隠してる埋蔵金もある。政府は非常用の災害対策費だと言って毎年こっそり巨額の資金を積み立てて隠し持っているだろ?
民主党政権の時は、その金を使って子供手当や高速道路の値下げを実現させたぞ?
一部の右翼勢力からは「露骨なバラまき政策だ」と批判も受けたが、お小遣いをもらえた国民のウケは良かった。
ちなみにその後、3.11が起こった時には埋蔵金をすべて使い果たしてて大変だったみたいだけどな!
デフレの原因が貯蓄格差の拡大にある。これを加速しているのが消費税。
貯蓄が増える速度よりも多く、貨幣供給のスピードを上げないとデフレ脱却はできない。
政府はここ30年国債という形で銀行や保険屋にゼロリスクの利益を与え続けている。
政府は通貨発行をサボることで銀行や保険屋に税金を垂れ流している。
年間10兆円がゼロリスクで金持ちにばらまかれている。
何がバランスだよ。
MMTみたいな近代経済理論を前にすると、最早「麻生太郎の語る財政均衡」は本当に化石にしか思えない。
コンピュータvs紙とペンの世界観。他の国だって真剣に取り上げてるんだから、せめて検証ぐらいしろよ。
要するに国債発行して無限に日銀に買い取って貰えばいいんだよ
高額所得者個人の税率増とか社会福祉増なんて太郎言ってたっけ?
法人税率上げるのと国債発行で歳入を担保し、市場マネーを増やしてインフレさせる、っていう政策だったよね?
自民の経済政策よりは正しい気がするけど、むしろ共産党と選挙協力してたことの方が致命的だわ。
貧乏人は色々言うけど一番金払ってるのは金持ちや法人だからな
ほんとありえないぐらい税金で持ってかれてるから。国を支えてるのは金持ちだよ
で、そいつらが海外に逃げると困るわけ。だから金持ちの優遇してんだよ
そりゃ金持ちは貧乏人のこと考えてないけど、貧乏人だって金持ちのこと考えてない
いくらでも出る打出の小槌ぐらいに思ってるからお相子だぞ
だったら消費税増やすなよカス
負担だけ増えているだろ
法人税が上がったら従業員減らすしかないなぁ
MMTを全く理解していない麻生太郎
落ちぶれたなあ
だからなんで消費税なんだよゴミ麻生
財源について具体的に言わない奴全員詐欺師
そこで、埋蔵金の出番ですよwww
消費増税は国際的な要請なんだが、埋蔵金信じるような馬鹿は理解できないだろうな
できないこと言って票をとるのは詐欺と一緒
支持してる人たちはミンスのこともう忘れたんですかね
じゃあ公務員にボーナス出すなよゴミクズ、経済をどうにかしないと税収が減るのにゲリのミクス大失敗で逆に貧困化してんだけど?
一時期この成金ゴミムシをローゼンとか持ち上げてたカスキモオタは貧乏になってどうしちゃってんの?
これは麻生が完全にまと外れ。山本は基本的には法人税と所得税の累進性を上げろと言ってるし、財政拡大で経済成長を促せともはっきり主張してる。んで財政拡大についてもMMTだけでなく主流派の経済学者も主張してるし、日本よりインフレ率の高いアメリカの保守派が大好きなトランプもガンガン赤字拡大してる。
やっぱり麻生は完全に耄碌してるな。誰かに脅迫でもされてんのか?中川みたいにするぞ!とか言われてるんじゃね?